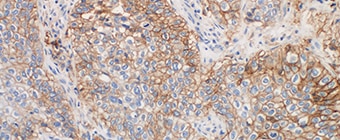
NSCLC training teaser image
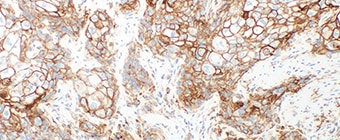
UC training teaser image

The PD-L1 IHC 28-8 pharmDx interpretation training is a comprehensive program with in-depth content and practice cases focused on helping pathologists to:
- Understand the role of immune checkpoint pathways
- Learn about technical considerations for optimal slide staining results
- Learn how to evaluate NSCLC, non-squamous NSCLC, SCCHN and UC specimens stained with PD-L1 IHC 28-8 pharmDx
Intended Use
For in vitro diagnostic use.
PD-L1 IHC 28-8 pharmDx is a qualitative immunohistochemical assay using Monoclonal Rabbit Anti-PD-L1, Clone 28-8 intended for use in the detection of PD-L1 protein in formalin-fixed, paraffin-embedded (FFPE) non-small cell lung cancer (NSCLC), squamous cell carcinoma of the head and neck (SCCHN), and urothelial carcinoma (UC) tissues using EnVision FLEX visualization system on Autostainer Link 48.
PD-L1 protein expression is defined as the percentage of evaluable tumor cells exhibiting partial or complete membrane staining at any intensity.
Companion Diagnostic Indication
|
Tumor Indication |
PD-L1 Expression Clinical |
Intended Use |
|
NSCLC |
≥ 1% tumor cell expression |
PD-L1 IHC 28-8 pharmDx is indicated as an aid in identifying NSCLC patients for treatment with OPDIVO® (nivolumab) in combination with YERVOY® (ipilimumab). |
PD-L1 expression (≥ 1% or ≥ 5% or ≥ 10% tumor cell expression), as detected by PD-L1 IHC 28-8 pharmDx in non-squamous NSCLC may be associated with enhanced survival from OPDIVO®.
PD-L1 expression (≥ 1% tumor cell expression), as detected by PD-L1 IHC 28-8 pharmDx in SCCHN may be associated with enhanced survival from OPDIVO®.
PD-L1 expression (≥ 1% tumor cell expression), as detected by PD-L1 IHC 28-8 pharmDx in UC may be associated with enhanced response rate from OPDIVO®.
See the OPDIVO® and YERVOY® product labels for specific clinical circumstances guiding PD-L1 testing.